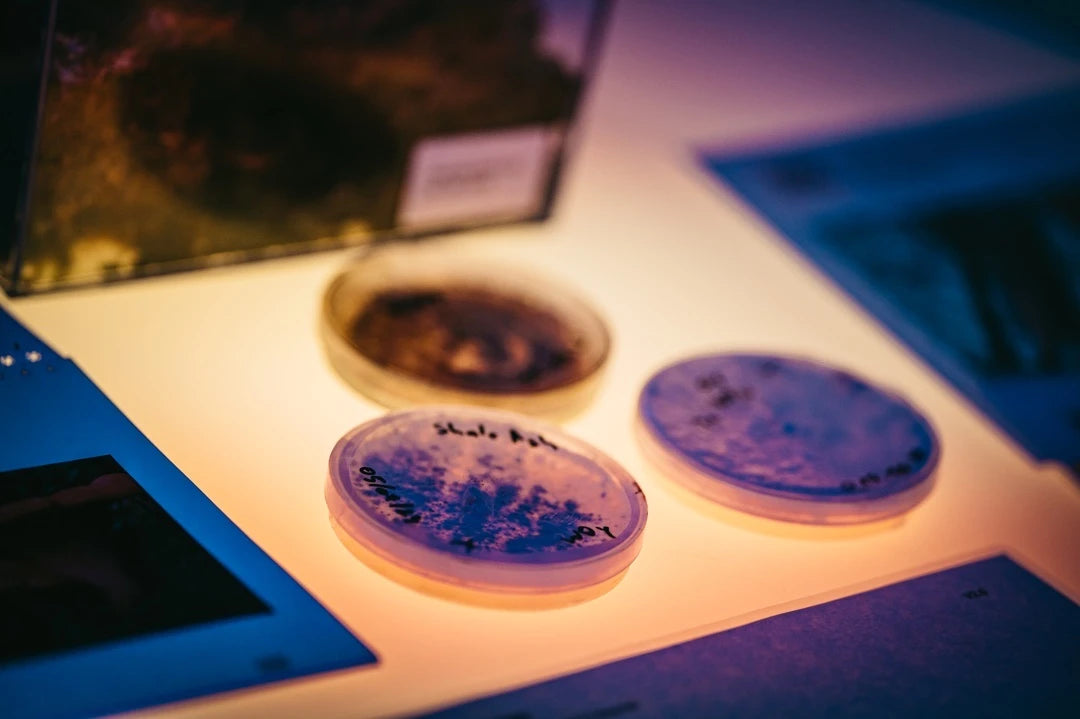

OUR STORY
We are a company from Estonia that works with functional mushrooms and fungi to make wellness products and environmental solutions.
We have been doing this for 10 years.
Siim Kabrits - Founder

WHAT WE DO
Shroomwell grows a lot of Chaga mushrooms outdoors - the most in the world, as we have big farms in Estonia, Sweden, and the USA, 700 hectares to be honest.
We also grow functional mushrooms inside a big factory in Tõrva, Estonia, making Shroomwell the biggest indoor mushroom growers in the North.
We use old knowledge and new science technologies like ultrasonic assisted extraction (UAE), to do something good for people and our planet.

FORMERLY CHAGA HEALTH
We are formerly known as Chaga Health. We were initially founded in 2014, but rebranded to Shroomwell in 2023.
Chaga Health → Shroomwell

OUR GOALS
We want to use mushrooms to make products that help people feel better and live healthier.
We also want to help our planet through mycotehnology with environmental solutions.
Our big dream is to make the world a better place and people by with our products and solutions.
PIONEERING A HEALTHIER TOMORROW
At Shroomwell, we are committed to shaping a future where health and sustainability go hand in hand.
If this resonate with you, join us.
